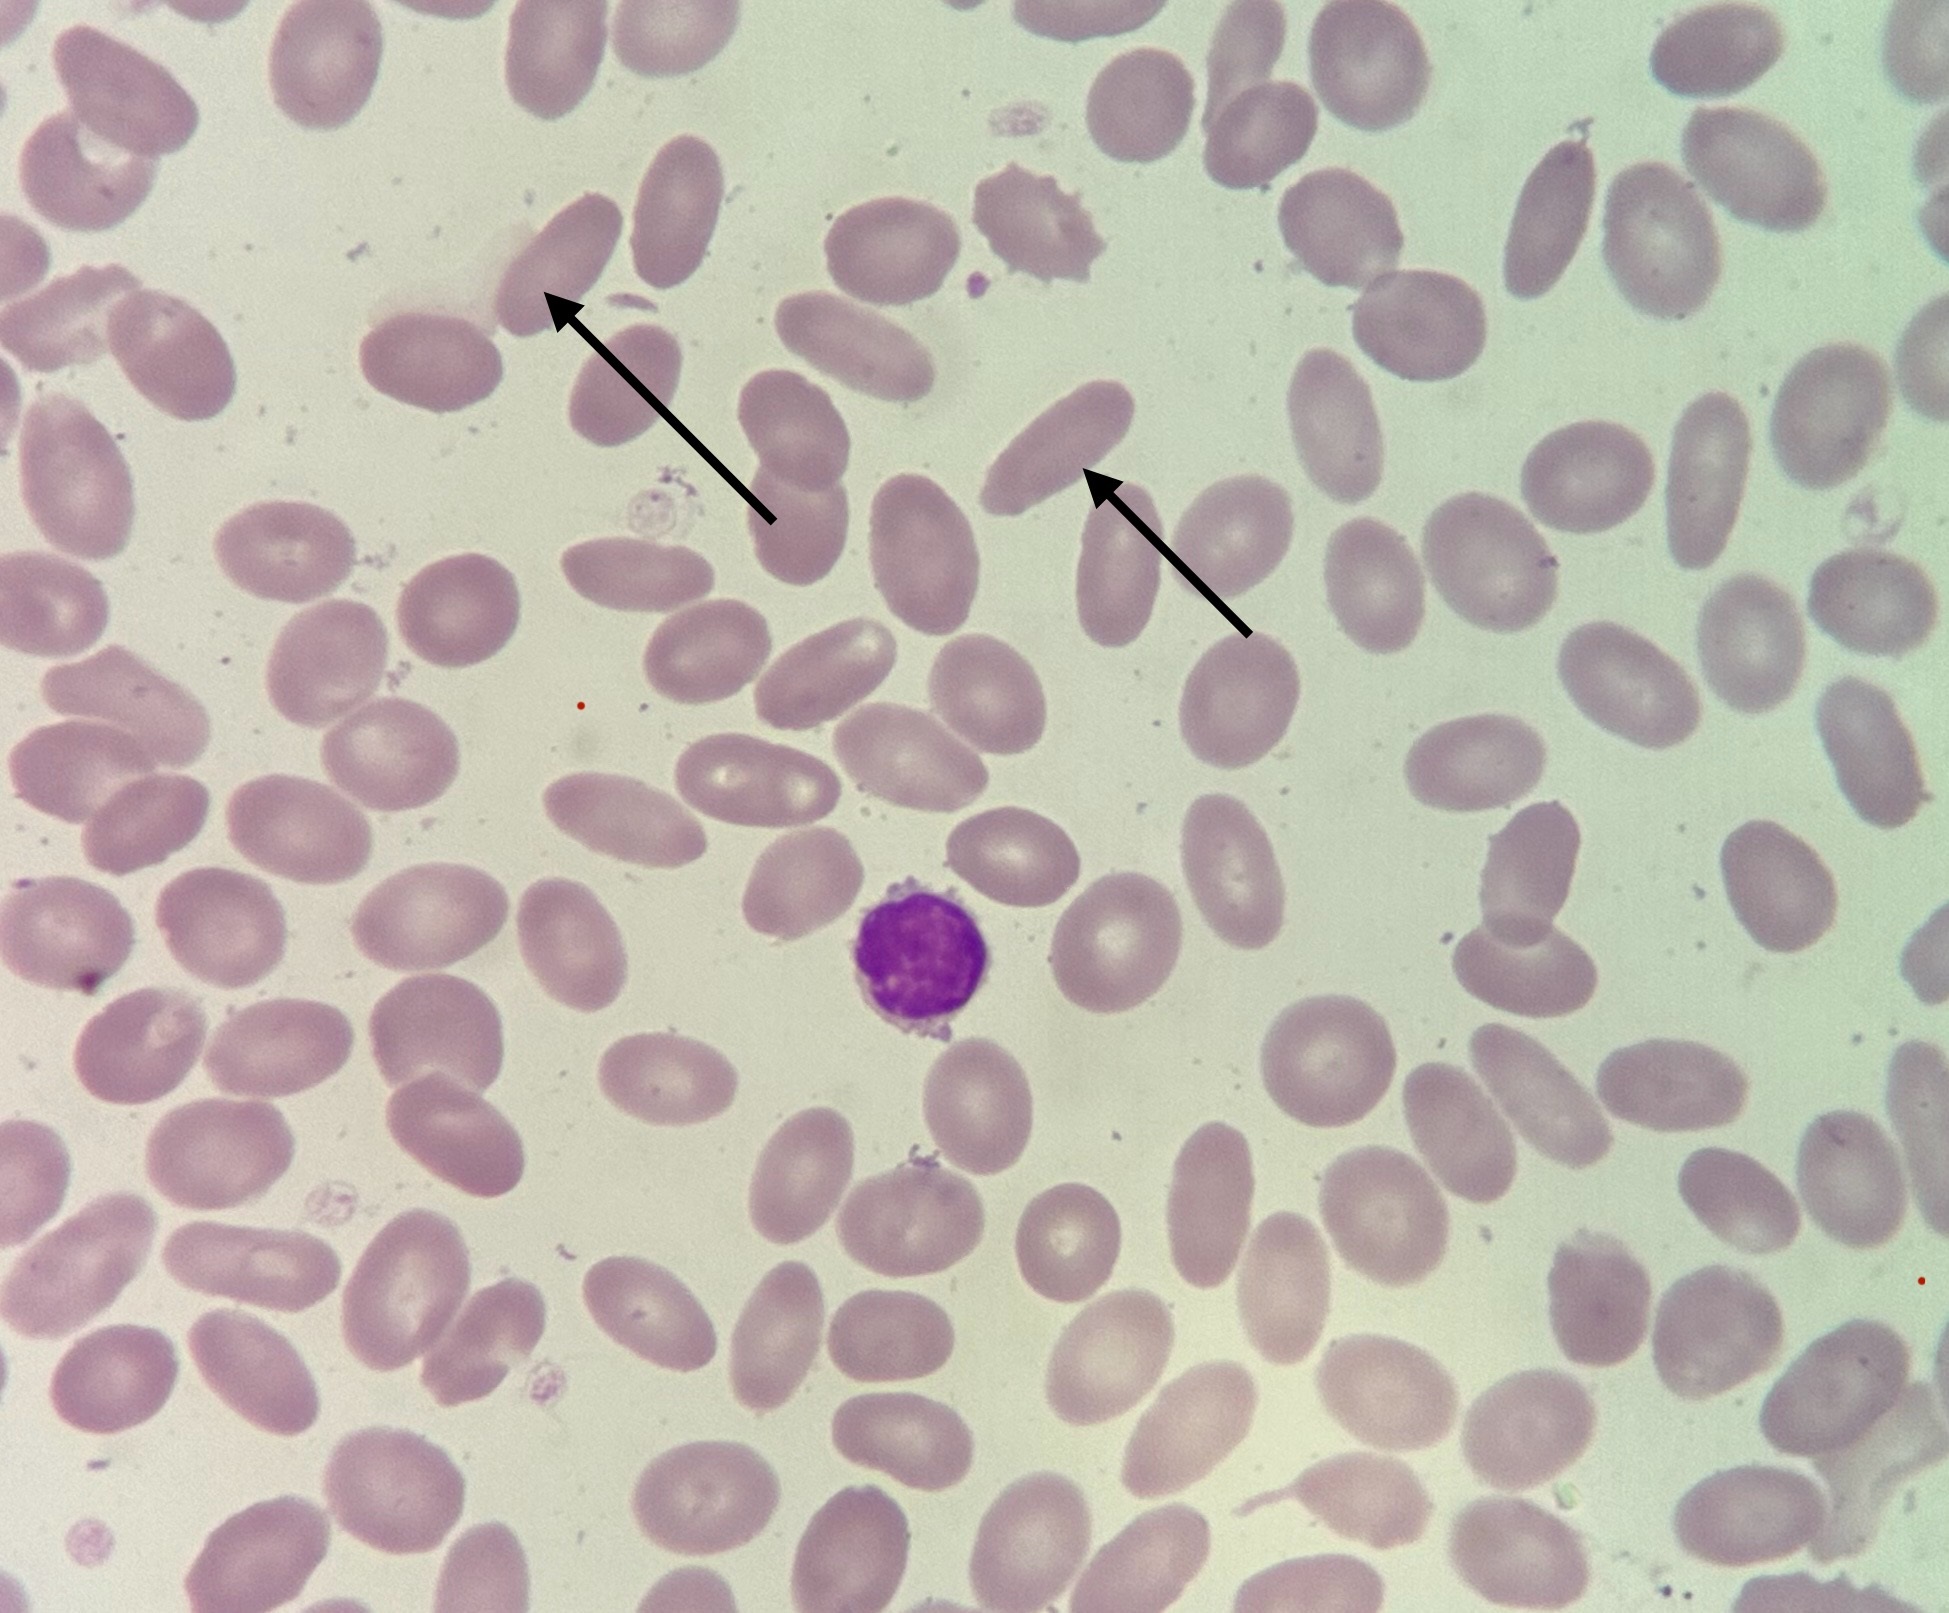

Что значит эритроциты у собаки
Что значит эритроциты у собаки 106 фотографий
Форека перми на 10 дней
Вести 16 08 16
Готовим перец фаршированный мясом в кастрюле
Трансляция совета оон
Как делать домашнюю брагу
Сколько министерств в правительстве
Собрать розы по спирали
Сообщение о живописи кратко
Московское ш 84
Золотые правила еврохим